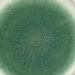
Lietuvos mokslininkai tiria mikroskopinių grybų paslaptis ir naudą | Lietuvos agrarinių mokslų ir miškų centro Žemdirbystės instituto nuotr.

Kiekvieną dieną I–V 09–18 val., į Klaipėdos etnokultūros centro salėje, Daržų g. 10, vykstančią parodą „Sakralumo jungtys. Kalviškoji kryždirbystė ir šiaudiniai sodai“, kviečia Klaipėdos etnokultūros centras.
Paroda veiks iki š. m. rugsėjo 15 d. Rengėjai kviečia ateiti ir išvysti šiaudų lengvumo bei solidaus metalo nematytą bendrystę. Vaizdas magiškas! Kviečiama susipažinti artimiau su šiais išskirtiniais papročiais.
Kaltiniai kryžiai ir saulutės
Tai mažosios architektūros paminklų viršūnės, atskleidžiančios tradicinių saulučių vaizdinį grožį, formų įvairovę, jose simboliškai užkoduotą prasmę.
Kalviškoji kryždirbystė – neatsiejama dalis Lietuvos kryždirbystės meno, kurį prieš dvidešimt metų UNESCO įtraukė į Žmonijos žodinio ir nematerialaus paveldo šedevrų sąrašą.
Parodoje, kuri Klaipėdos etnokultūros centre veiks iki rugsėjo pradžios, galima išvysti visą šiuolaikinės kalviškosios kryždirbystės Lietuvoje įvairovę, atstovaujamą žymiausių Lietuvos kalvių iš visų etnografinių Lietuvos regionų.
Paroda suformuota iš kūrinių, sukurtų meninės kalvystės kūrybinėse stovyklose Užventyje ir klaipėdiškio G. Černiausko darbų. Rodomos 34 geležinių kryžių viršūnės.
pakruojo.krastas.lt nuotr.
Autoriai: A. Degė, R. Gudaitis, A. Sodaitis, S. Špukas (Radviliškis), R. Grekavičius (Kaunas), A. Janulis (Ukmergė), A. Jukumas (Klaipėda), J. Kavaliauskas (Druskininkai), S. Kronis (Panevėžys), E. Latėnas (Vilnius), V. Mikuckis, Č. Pečetauskas, E. Sinkevičius (Mažeikiai),
T. Pacaitis (Lazdijai), E. Pokvytis (Plungė), E. Rimkūnas, V. Slavinskas (Telšiai), D. Vilius (Šilutė), E. Vronskis (Daugpilis, Latvija) ir G. Černiauskas (Klaipėda). Vieni jų artimai seka senąją tradiciją, kiti ją interpretuoja kiek laisviau.
Kalviškosios kryždirbystės paprotys, lietuviui yra ne tik religinio, bet ir tautinio tapatumo išraiška.
Šiaudų sodai
Viena lietuvių paprotinės liaudies dailės rūšių. Tai tūriniai griežtos geometrinės formos dirbiniai, turintys estetinę ir šventą paskirtį.
Vyrauja keturšlaitės piramidės silueto ir iš jos kilusios sudėtingesnės struktūros, taip pat sutinkamos žvaigždės, skritulio formos.
Labiausiai paplitusį sodų pavidalą sudaro oktaedras – dvigubos vieno keturkampio perimetro piramidės, kurių viršūnės simetriškai nukreiptos į viršų ir apačią.
Puošiami jie tradiciniais gyvybę, vaisingumą, turtingumą simbolizuojančiais bruožais.
Sodai yra svarbi senąją pasaulėžiūrą atspindinti lietuvių ir baltų kultūros paveldo dalis, todėl jie prilygintini universaliam Pasaulio medžio – darnios visatos – simboliui: vertikalioje ašyje jis atspindi dangaus–žemės–požemio, praeities–dabarties–ateities modelį, o horizontalėje – keturias pasaulio šalis.
Parodoje rodoma 50 šiaudinių sodų iš visos Lietuvos. Tradicinių sodų meistrės Marijos Liugienės įkvėpti ir paraginti šiaudinius sodus riša didelis būrys mėgėjų.
Parodoje galime grožėtis 33 meistrų kūriniais: R. Dubakienės, R. Gelčienės, R. Ivanauskienės, J. Matuzonienės, D. Norvaišienės, R. Petkevičienė., A. Steikūnienės, R. Rotkevičiaus, N. Pivorienės, E. Kakaškienės, R. Lichadziauskienės, V. Bitinaitės-Stankevičienės, M. Liugienės (Vilnius), J. Aleknavičiaus (Vilnius raj,), V. Pugačiauskienės, A. Ilickienės (Varėnos r.),
Z. Indriūnienės, I. Eitminavičienės, M. Rinkevičienės, R. Tutinienės (Utena), V. Riaubaitės-Mikelionienės (Kaunas), J. Bytautės (Zapyškis, Kauno raj.), V. Sniečkuvienės (Vilkija), A. Narkevičiaus, A. Narkevičiūtės, J. Šlajienės (Jonava), D. Lengvinaitės (Klaipėdos r.), R. Družienės (Panevėžio r.), B. Šeputienės (Skuodas), V. Šurnaitės (Joniškis), L. Rudžionienės (Kauno r.), J. Jauniuvienės (Šilutė), M. Macijauskienės (Klaipėda).

Ar galėčiau nusipirkti vieną iš sodų? Jie man yra kažkokie paslaptingi. Ačiū